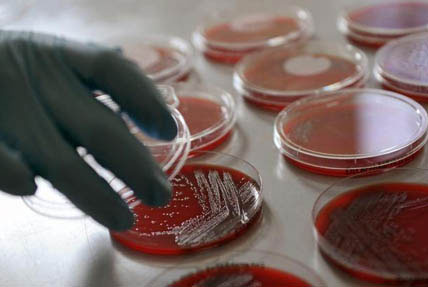
Szakemberhiánnyal küzd a német ipar

Hasmenés-járvány Németországban
- Irány Németország!
- Témaindító
- Látogató
-
Minden antibiotikumnak ellenáll
A hatóságok szerint egy különleges bélbaktérium által okozott fertőzésben több tartományban már legkevesebb 140-en betegedtek meg, és 160-nál is több a gyanús esetek száma. A megbetegedettek közül mintegy 40 személy életveszélyes állapotban van. Az úgynevezett EHEC-bélbaktérium nem először ütötte fel a fejét Németországban, a járvány ezúttal május közepén kezdődött. Az első értékelések szerint azonban terjedése gyorsabb, mint korábban. Az egészségügyi hatóságok egyelőre sötétben tapogatódznak azzal kapcsolatosan, hogy valójában mi okozza a járványt. Szokatlannak számít az is, hogy a fertőzés elsősorban felnőtt nőket érint. Mindez megerősíti azt a gyanút, hogy a fertőzés forrását bizonyos élelmiszerek - a többi között mosatlan zöldég, illetve gyümölcs - jelenthetik. A megbetegedés általában véres hasmenéssel jár, és tünetei között van fejfájás, általános levertség és láz is. Súlyosabb formájában, illetve gyengébb szervezetek esetében veseelégtelenséget is okozhat. A baktérium veszélyességét növeli, hogy az eddigi tapasztalatok szerint ellenáll minden antibiotikumnak. A hatóságok szerint mindezt tetézi, hogy a fertőzés emberről emberre is terjed. A hatóságok fokozott elővigyázatosságra, a higiéniai szabályok fokozottabb betartására, illetve a már megfertőzött vagy gyanús személyek elkülönítésére szólítottak fel a lakosságot. (MTI) Fotó: dpa
Kérjük, hogy Bejelentkezés vagy , hogy csatlakozhass a beszélgetéshez!








